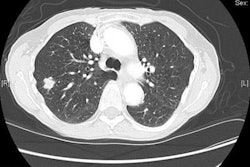
2017 03 01 15 23 43 165 Sa5 Lung Cancer Screening Image 20170301222409

DUBAI - Although yet to be implemented, the 2015 draft Health Authority Abu Dhabi (HAAD) Guidelines for CT lung cancer screening were the subject of much debate at Wednesday's thoracic imaging session during the Total Radiology conference at Arab Health 2017.
Dr. Naghma Erum Nawaz from Abu Dhabi, United Arab Emirates.The dialogue centered around the background and rationale for CT lung cancer screening, including an overview of the role of low-dose CT in lung cancer screening and the potential impact that it can have for Arab countries that have yet to implement their own screening guidelines.
The aim of any screening test should be to catch disease in the detectible preclinical phase, and the critical aspect is the point in the natural history of the disease before which therapy is more effective, according to Dr. Naghma Erum Nawaz, deputy chair of radiology and program director of the radiology residency program at Sheikh Khalifa Medical City in Abu Dhabi, United Arab Emirates.
"The ideal screening test is based on certain disease characteristics, namely that the disease is prevalent and serious, and therefore significantly impacts public health," she explained. "The underlying message is that treatment of presymptomatic disease is more effective than treatment after the symptoms develop."
The big picture
Lung cancer statistics from the American Cancer Society estimate there are 1.1 billion active smokers in the world, and about half will die due to the health consequences of smoking, Nawaz explained. According to the U.S. National Institutes of Health, lung cancer is the costliest cancer to society, with indirect annual costs estimated at $36 billion U.S. (33 billion euros).
Meanwhile, the U.S. National Cancer Institute estimates that 75% of patients presenting with advanced local or metastatic lung cancer will die. The five-year survival rate is 17.4%, compared with 99.7% for prostate and 90.3% for breast cancer -- an unsurprising statistic given that early-stage lung cancers develop asymptomatically and only 8% of stage III and IV tumors were operatively managed in 2014, she noted.
Evidence shows a history of smoking is the single most important causative factor for lung cancer, with 85% of new cases diagnosed in current or former smokers. The lifetime risk of a heavy smoker is 18.5% to 24.4%, compared with 0.2% to 1.4% for someone who has never smoked.
"Also referred to as environmental tobacco smoke, secondhand smoke has been identified as a significant risk factor for lung cancer in the case of never smokers," Nawaz said. "Experts estimate that 15% to 35% of lung cancer cases among never smokers are associated with [environmental tobacco smoke]."
Other environmental factors include exposure to radon, asbestos, pesticides, heavy metals, and air pollutants, as well as age, which is a significant risk factor as the average age at diagnosis is 70.
The ideal test?
The U.S. National Lung Screening Trial (NLST) in 2011 compared two ways of detecting lung cancer: low-dose CT and standard chest x-ray.
In her talk, Nawaz outlined the primary study findings of NLST, which revealed there is a 20% lower risk of lung cancer mortality with low-dose CT and a 6.7% reduction in all-cause mortality with the modality. As a result, 7.6% of all U.S. lung cancer deaths each year could be averted, suggesting there is adequate evidence to indicate annual screening with low-dose CT can prevent a substantial number of lung cancer deaths among high-risk patients.
As a result of the NLST study, a number of different guidelines have recommended annual screening with low-dose CT for select patients, with most suggesting those in an age range between 55 and 80 years old with a history of heavy smoking or individuals who have quit within 15 years, she continued.
The main risk of screening is overdiagnosis, as positive findings were detected in 24.2% of low-dose CT studies, with further studies revealing that more than 95% of these were benign on further examination, according to Nawaz. Interestingly, lung cancer screening has only an 18% overdiagnosis rate, compared with 30% to 54% with breast cancer screening and 29% to 44% with prostate cancer screening.
In addition, subsequent retrospective analysis of the results from the International Early Lung Cancer Action Program (I-ELCAP) showed that increasing the threshold size at which nodules are worked up to 6 mm (rather than 4 mm in the NLST study) reduced the number of false-positive findings by half without compromising cancer detection.
Dr. Michael Fuchsjäger, professor and chair of radiology at Medical University of Graz in Austria, is the global head of Total Radiology."With the higher threshold, only 12% of screening subjects can expect to return for follow-up imaging, and approximately 6% will need further evaluation that may require referral to a multidisciplinary clinic," Nawaz said. "Also, the availability of prior chest CT studies at the time of reporting helps radiologists assess the stability of positive findings and, thus, reduces the possible need for follow-up."
Despite not yet being implemented, the Abu Dhabi's HAAD Guidelines for Lung Cancer Screening & Diagnosis are supported by the American Cancer Society, American College of Chest Physicians, American Society of Clinical Oncology, and U.S. National Comprehensive Cancer Network. The guidelines cover everything in the international guidelines with one additional risk factor: a 20-year history of water pipe (or shisha) use, due to the popularity of this form of tobacco in the region.
The HAAD guidelines also indicate the only centers in Abu Dhabi allowed to refer patients for lung cancer screening are the Ambulatory Health Services (the primary health centers in the city), and screening must take place at Sheikh Khalifa Medical City or the Cleveland Clinic in Abu Dhabi or Tawam Hospital in Al Ain.